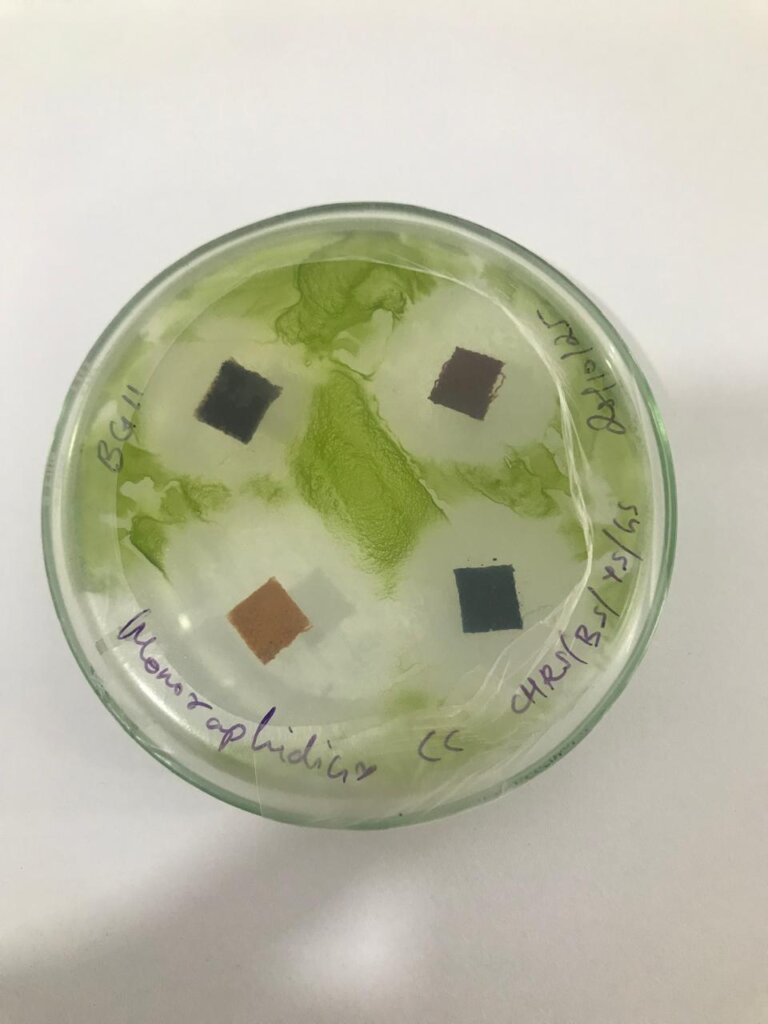

Microalgae Research, Consultancy, Training & Collaborations
AlgagenBio specializes in microalgae research and development, offering integrated consultancy, training, and collaborative innovation services. Our R&D work focuses on microalgae strain optimization, sustainable cultivation systems, and algae-based product development for aquaculture, environmental management, and biotechnology industries. We partner with academic institutions, startups, and industrial organizations to deliver scalable, science-driven microalgae solutions.
Academic Research &
Student Support Programs
AlgagenBio provides expert guidance for undergraduate and postgraduate academic projects, dissertations, and internship programs in microalgae and biotechnology.

PG Dissertations
Advanced research support for postgraduate dissertations with a focus on experimental design, data analysis, and industry-aligned microalgae studies.
Academic Projects
Mentored academic projects in microalgae and biotechnology with a strong emphasis on practical, application-driven research.


UG Dissertations
Hands-on guidance for undergraduate projects in microalgae, covering culturing techniques, data collection, and applied biotechnology research.
Internship Programs
Structured internship programs offering practical exposure to microalgae research, laboratory workflows, and real-world biotechnological applications.


Molecular Taxonomy Services for Microalgae Identification
AlgagenBio provides molecular taxonomy services for accurate microalgae identification and classification using advanced molecular techniques. These services support biodiversity studies, strain authentication, regulatory compliance, and research validation. Reliable molecular taxonomy is essential for academic research and industrial applications requiring precise strain documentation.

Microalgae Consultancy: Strain Selection, Culturing & Product Development
We offer end-to-end microalgae consultancy services, including strain selection, culturing protocols, screening, and algae-based product development. AlgagenBio also delivers industrial wastewater and bio-effluent treatment using microalgae, enabling sustainable nutrient recovery and environmental remediation. Our solutions support industries seeking eco-friendly wastewater treatment and circular bioeconomy models.
Microalgae Based Toxicity Studies & Bioremediation
We harness the power of microalgae to drive eco-friendly innovation. We conduct toxicity studies using microalgae to assess the environmental safety of products for various applications, ensuring compliance and sustainability. Additionally, our microalgae technologies are deployed for bioremediation of wastewater, reducing pollutants and recovering valuable biomass, as well as CO₂ sequestration, capturing and converting emissions into useful biomass. Let us help you turn environmental challenges into sustainable opportunities.



